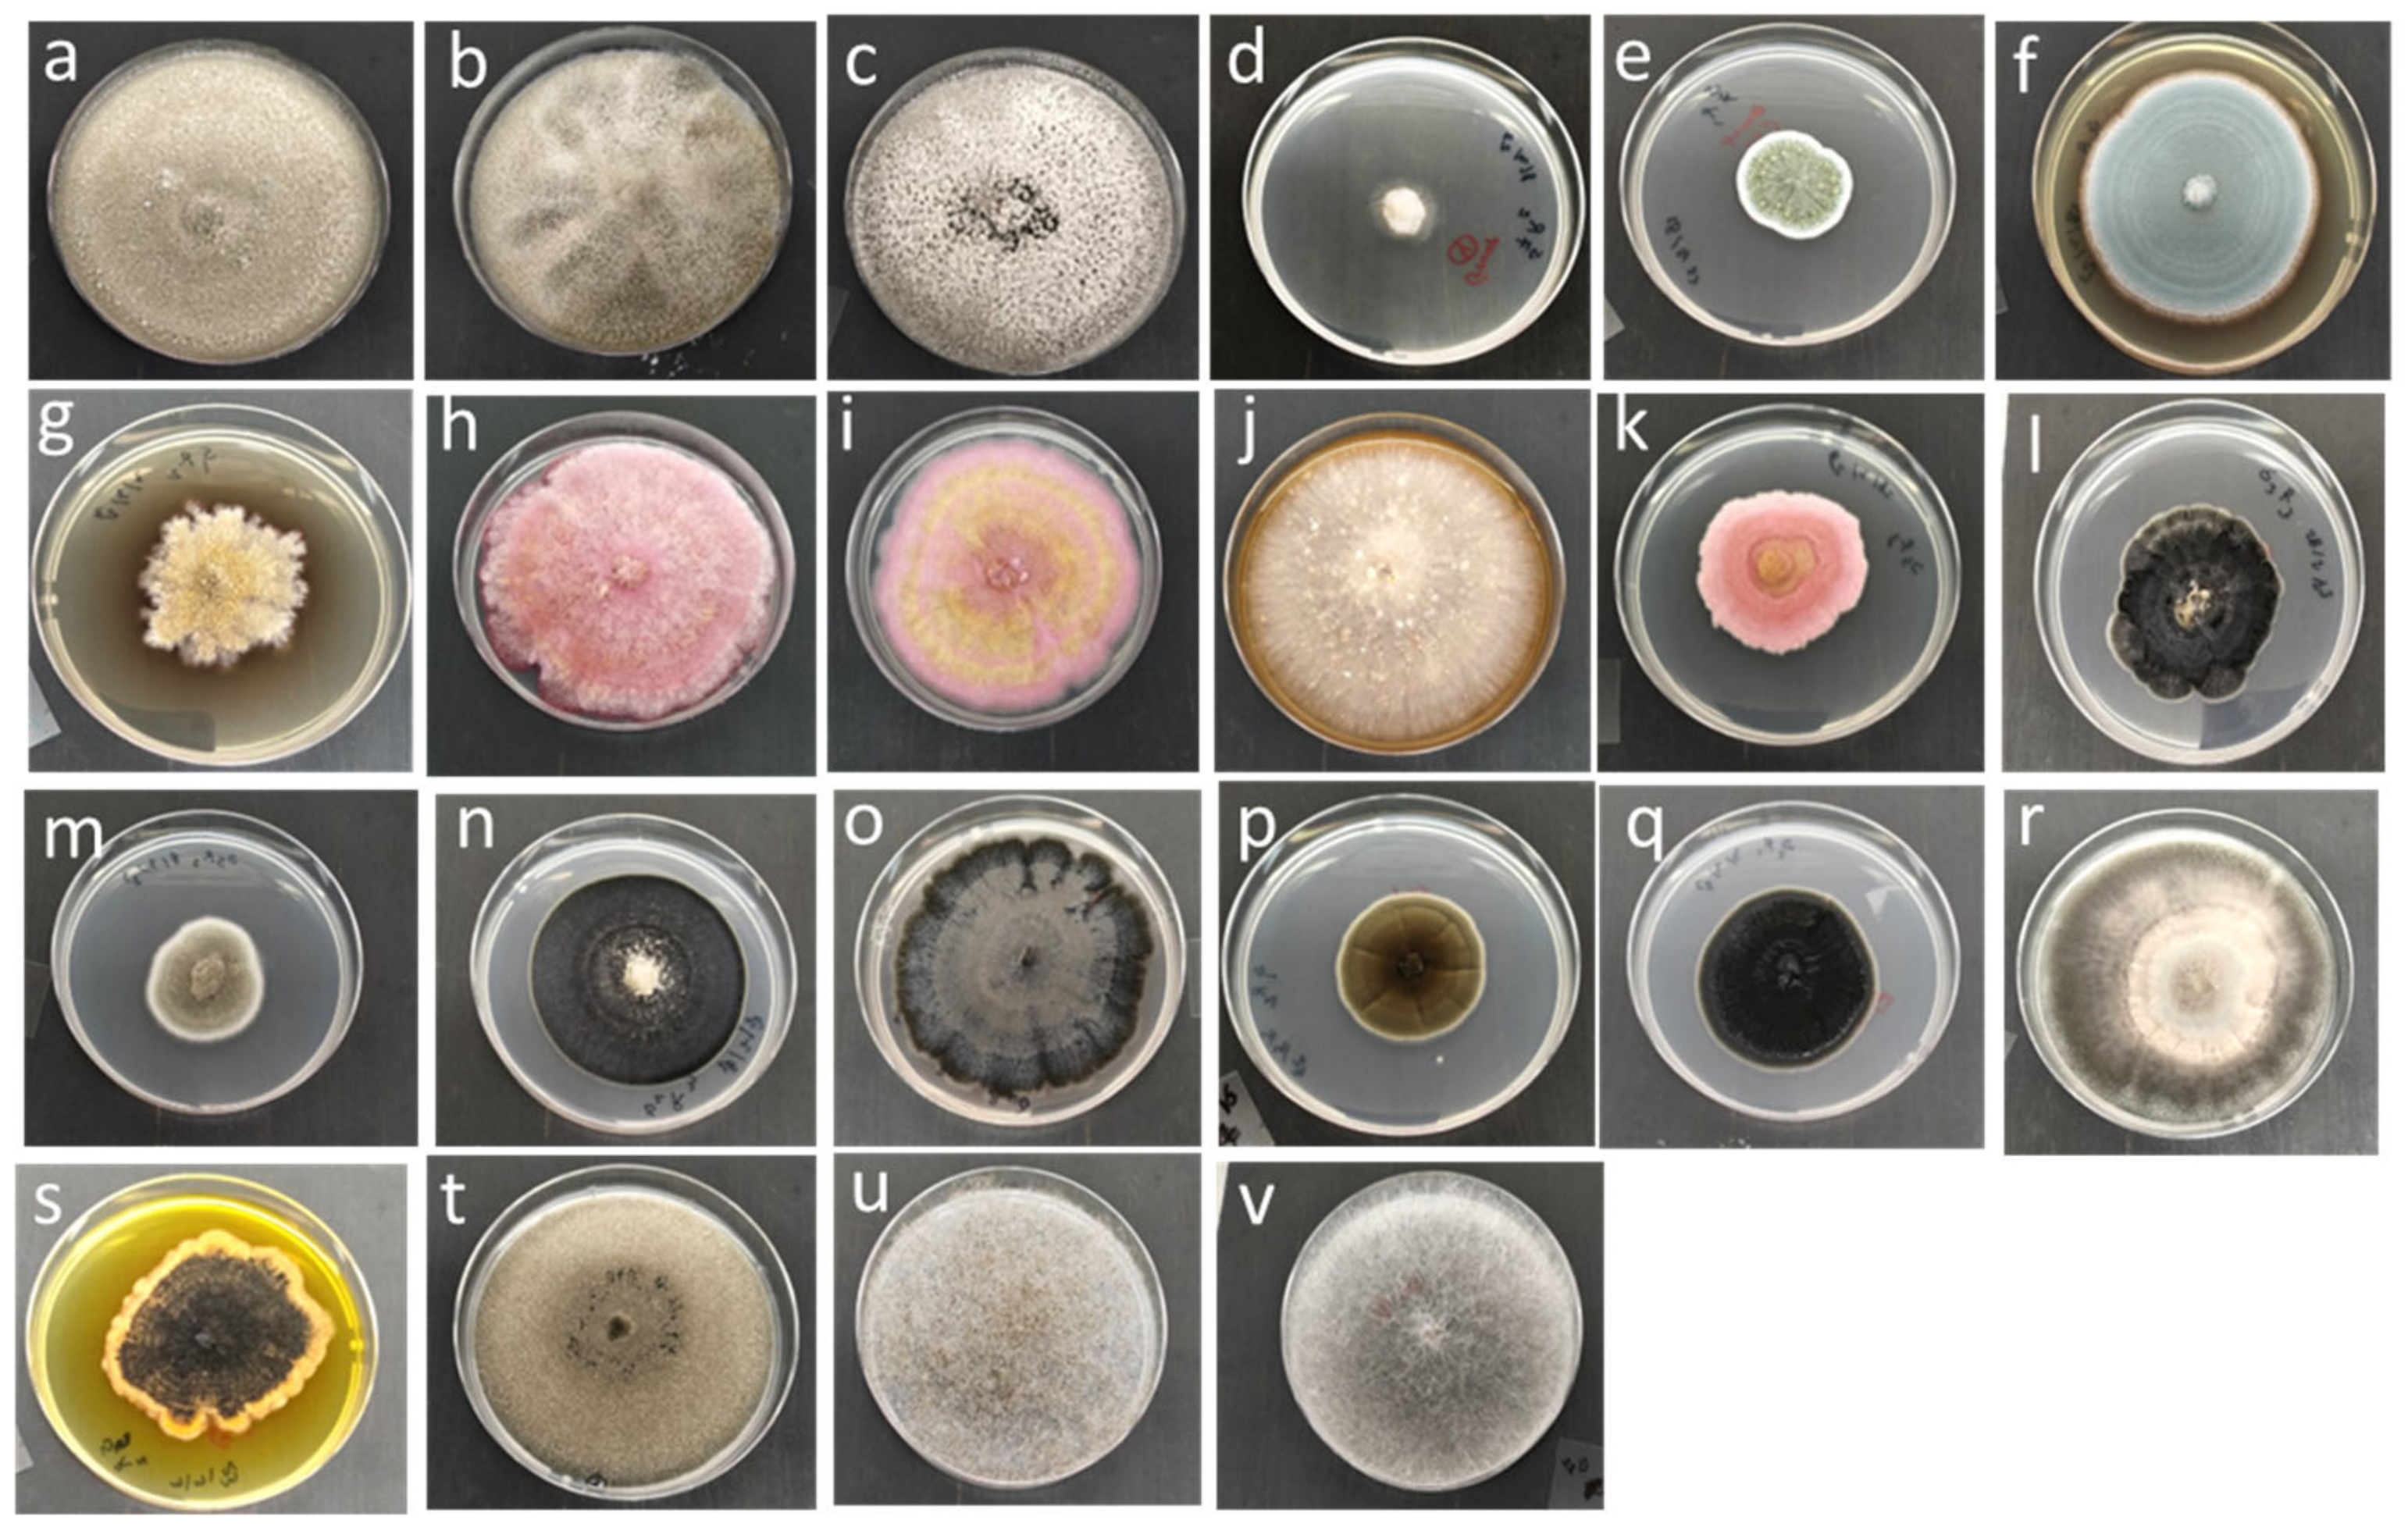
Agriculture 15 00748 g001

A Novel Approach for Fungal Control with Ethyl Formate in Barley and Its Impact on Germination
Abstract
:1. Introduction
2. Materials and Methods
2.1. Grain Sample Collection
2.2. Chemical Reagents
2.3. Isolation and Identification of Fungi
2.4. Fumigation
2.5. Chemical Analysis of Fumigants
2.6. Barley Germination Test
2.7. Statistical Data Analysis
3. Results
3.1. Isolation and Identification of Barley Fungi
3.2. Inhibition of Ethyl Formate and Formic Acid Against Fungal Strains
3.3. Effect of EF on Barley Germination
3.3.1. Vigor and Germination Rate of Barley
3.3.2. Root and Plumule Lengths
4. Discussion
5. Conclusions
Supplementary Materials
Author Contributions
Funding
Data Availability Statement
Acknowledgments
Conflicts of Interest
References
- Dong, X.; Sun, L.; Agarwal, M.; Maker, G.; Han, Y.; Yu, X.; Ren, Y. The effect of ozone treatment on metabolite profile of germinating barley. Foods 2022, 11, 1211. [Google Scholar] [CrossRef] [PubMed]
- Xiao, Y.; Gu, C.; Yu, J.; Shan, C.; Ren, Y. A novel method for analysis of phosphine (PH3) residues in canola and cottonseed. Curr. Microw. Chem. 2018, 5, 155–159. [Google Scholar]
- Hao, G.; McCormick, S.; Usgaard, T.; Tiley, H.; Vaughan, M.M. Characterization of three Fusarium graminearum effectors and their roles during Fusarium head blight. Front. Plant Sci. 2020, 11, 579553. [Google Scholar]
- Cao, D.; Lou, Y.; Jiang, X.; Zhang, D.; Liu, J. Fungal diversity in barley under different storage conditions. Front. Microbiol. 2020, 13, 895975. [Google Scholar]
- Braga, R.M.; Padilla, G.; Araújo, W.L. The biotechnological potential of Epicoccum spp.: Diversity of secondary metabolites. Crit. Rev. Microbiol. 2018, 44, 759–778. [Google Scholar]
- Woudenberg, J.H.C.; Groenewald, J.Z.; Binder, M.; Crous, P.W. Alternaria redefined. Stud. Mycol. 2013, 75, 171–212. [Google Scholar]
- Nguyen, T.T.; Kim, J.; Jeon, S.J.; Lee, C.W.; Magan, N.; Lee, H.B. Mycotoxin production of Alternaria strains isolated from Korean barley grains determined by LC-MS/MS. Inter. J. Food Microbiol. 2018, 268, 44–52. [Google Scholar]
- Khan, M.K.; Pandey, A.; Athar, T.; Choudhary, S.; Deval, R.; Gezgin, S.; Hamurcu, M.; Topal, A.; Atmaca, E.; Santos, P.A.; et al. Fusarium head blight in wheat: Contemporary status and molecular approaches. 3 Biotech 2020, 10, 172. [Google Scholar]
- Ons, L.; Bylemans, D.; Thevissen, K.; Cammue, B.P. Combining biocontrol agents with chemical fungicides for integrated plant fungal disease control. Microorganisms 2020, 8, 1930. [Google Scholar] [CrossRef]
- Köhler, H.R.; Triebskorn, R. Wildlife ecotoxicology of pesticides: Can we track effects to the population level and beyond? Science 2013, 341, 759–765. [Google Scholar]
- Mostafalou, S.; Abdollahi, M. Pesticides and human chronic diseases: Evidences, mechanisms, and perspectives. Toxicol. Appl. Pharmacol. 2013, 268, 157–177. [Google Scholar] [PubMed]
- Handford, C.E.; Elliott, C.T.; Campbell, K. A review of the global pesticide legislation and the scale of challenge in reaching the global harmonization of food safety standards. Integr. Environ. Assess. Manag. 2015, 11, 525–536. [Google Scholar]
- Allen, B.; Wu, J.; Doan, H. Inactivation of fungi associated with barley grain by gaseous ozone. J. Environ. Sci. Health Part B 2003, 38, 617–630. [Google Scholar]
- Mylona, K. Fusarium Species in Grains: Dry Matter Losses, Mycotoxin Contamination and Control Strategies Using Ozone and Chemical Compounds. Ph.D. Thesis, Cranfield University, Wharley End, UK, 2012. [Google Scholar]
- Plumier, B.M.; Schramm, M.; Ren, Y.; Maier, D.E. Modeling post-fumigation desorption of phosphine in bulk stored grain. J. Stored Prod. Res. 2020, 85, 101548. [Google Scholar]
- Bluma, R.; Amaiden, M.R.; Etcheverry, M. Screening of Argentine plant extracts: Impact on growth parameters and aflatoxin B1 accumulation by Aspergillus section Flavi. Int. J. Food Microbiol. 2008, 122, 114–125. [Google Scholar]
- Zhang, S.; Zheng, M.; Zhai, H.; Lyu, Y.; Hu, Y.; Cai, J. Effects of hexanal fumigation on fungal spoilage and grain quality of stored wheat. Grain Oil Sci. Technol. 2021, 4, 10–17. [Google Scholar]
- Hocking, A.D.; Banks, H.J. Effects of phosphine fumigation on survival and growth of storage fungi in wheat. J. Stored Prod. Res. 1991, 27, 115–120. [Google Scholar]
- Savi, G.D.; Gomes, T.; Canever, S.B.; Feltrin, A.C.; Piacentini, K.C.; Scussel, R.; Oliveira, D.; Machado-de-Avila, R.A.; Cargnin, M.; Angioletto, E. Application of ozone on rice storage: A mathematical modeling of the ozone spread, effects in the decontamination of filamentous fungi and quality attributes. J. Stored Prod. Res. 2020, 87, 101605. [Google Scholar]
- Agarwal, M.; Ren, Y.; Newman, J.; Learmonth, S. Ethyl formate: A potential disinfestation treatment for eucalyptus weevil (Gonipterus platensis) (Coleoptera: Curculionidae) in apples. J. Econ. Entomol. 2015, 108, 2566–2571. [Google Scholar]
- Aharoni, Y.; Stewart, J.K.; Guadagni, D.G.; Mon, T.R. Thrips mortality and strawberry quality after vacuum fumigation with acetaldehyde or ethyl formate. J. Am. Soc. Hortic. Sci. 1980, 105, 926–929. [Google Scholar]
- Ryan, R.; Dominiak, B.C. Ethyl formate: Review of a rapid acting fumigant. In Proceedings of the 11th International Conference on Controlled Atmosphere and Fumigation in Stored Products (CAF2020), Winnipeg, Canada, 23–28 August 2020; Jayas, D.S., Jian, F., Eds.; CAF Permanent Committee Secretariat: Winnipeg, MB, Canada, 2021; pp. 269–275. [Google Scholar]
- Abo-El-Saad, M.M.; Badawy, M.E.; Shawir, M.S.; Hegazi, Y.H.; Mohammed, Y.M. In vitro and in vivo antimicrobial activity of the fumigant, ethyl formate, against bacteria and fungi of date fruits in postharvest phase. J. Food Meas. Charact. 2024, 18, 5791–5803. [Google Scholar] [CrossRef]
- Hassan, R.A.; Sand, M.I.; El-Kadi, S.M. Effect of some organic acids on fungal growth and their toxins production. J. Agric. Chem. Biotechnol. 2012, 3, 391–397. [Google Scholar] [CrossRef]
- Holmberg, T.; Kaspersson, A.; Larsson, K.; Pettersson, H. Aflatoxin production in moist barley treated with suboptimal doses of formic and propionic acid. Acta Agric. Scand. 1989, 39, 457–464. [Google Scholar] [CrossRef]
- Ren, Y.L. Natural levels of ethyl formate in stored grains determined using an improved method of analysis. J. Stored Prod. Res. 2004, 40, 77–85. [Google Scholar]
- Booth, C. The Genus Fusarium; Commonwealth Mycological Institute: Kew, UK, 1971. [Google Scholar]
- Booth, C. Fusarium. Laboratory Guide to the Identification of the Major Species; Commonwealth Mycological Institute: Kew, UK, 1977. [Google Scholar]
- Pitt, J.I. The Genus Penicillium and Its Teleomorphic States Eupenicillium and Talaromyces; Academic Press Inc. Ltd.: Cambridge, MA, USA, 1979. [Google Scholar]
- Pitt, J.I. A Laboratory Guide to Common Penicillium Species; Commonwealth Scientific and Industrial Research Organization, Division of Food Processing: Sydney, NSW, Australia, 1991. [Google Scholar]
- Moubasher, A.H. Soil Fungi in Qatar and Other Arab Countries; The Centre for Scientific and Applied Research, University of Qatar: Doha, Qatar, 1993. [Google Scholar]
- Samson, R.A.; Hoekstra, E.S.; Frisvad, J.C. Introduction to Food-and Airborne Fungi, 7th ed.; Centraalbureau voor Schimmelcultures (CBS): Utrecht, The Netherlands, 2004. [Google Scholar]
- Summerell, B.A.; Salleh, B.; Leslie, J.F. A utilitarian approach to Fusarium identification. Plant. Dis. 2003, 87, 117–128. [Google Scholar]
- Andjic, V.; Barber, P.A.; Carnegie, A.J.; Hardy, G.S.J.; Wingfield, M.J.; Burgess, T.I. Phylogenetic reassessment supports accommodation of Phaeophleospora and Colletogloeopsis from eucalypts in Kirramyces. Mycol. Res. 2007, 111, 1184–1198. [Google Scholar]
- Gardes, M.; Bruns, T.D. ITS primers with enhanced specificity for basidiomycetes-application to the identification of mycorrhizae and rusts. Mol. Ecol. 1993, 2, 113–118. [Google Scholar]
- White, T.J.; Bruns, T.; Lee, S.J.W.T.; Taylor, J. Amplification and direct sequencing of fungal ribosomal RNA genes for phylogenetics. PCR Protoc. A Guide Methods Appl. 1990, 18, 315–322. [Google Scholar]
- Sakalidis, M.L.; Hardy, G.E.S.; Burgess, T.I. Endophytes as potential pathogens of the baobab species Adansonia gregorii: A focus on the Botryosphaeriaceae. Fungal Ecol. 2011, 4, 1–14. [Google Scholar]
- Coetzee, E.M. Exploration of Ethyl Formate + Nitrogen as a Fumigant for Shipping Containers and Their In-Transit Fumigation. Ph.D. Thesis, Murdoch University, Murdoch, WA, Australia, 2020. [Google Scholar]
- Castañares, E.; da Cruz Cabral, L.; Dinolfo, M.I.; Andersen, B.; Stenglein, S.A.; Patriarca, A. Alternaria in malting barley: Characterization and distribution in relation with climatic conditions and barley cultivars. Int. J. Food Microbiol. 2021, 357, 109367. [Google Scholar]
- Sultan, A.; Frisvad, J.C.; Andersen, B.; Svensson, B.; Finnie, C. Investigation of the indigenous fungal community populating barley grains: Secretomes and xylanolytic potential. J. Proteom. 2017, 169, 153–164. [Google Scholar] [CrossRef] [PubMed]
- Chen, W.; Turkington, T.K.; Lévesque, C.A.; Bamforth, J.M.; Patrick, S.K.; Lewis, C.T.; Chapados, J.T.; Gaba, D.; Tittlemier, S.A.; MacLeod, A.; et al. Geography and agronomical practices drive diversification of the epiphytic mycoflora associated with barley and its malt end product in western Canada. Agric. Ecosyst. Environ. 2016, 226, 43–55. [Google Scholar] [CrossRef]
- Oksińska, M.P.; Magnucka, E.G.; Kmieć, A.; Pietr, S.J. Molecular identification of ascomycetes from American cranberry (Vaccinium macrocarpon Aiton) grown in plantation in Poland. Appl. Sci. 2024, 14, 4328. [Google Scholar] [CrossRef]
- Vipin, C.A. Identification of Loci Associated with Pleiochaeta Setosa in White Lupin. Master’s Thesis, Charles Sturt University, Bathurst, NSW, Australia, 2013. [Google Scholar]
- Babič, J.; Tavčar-Kalcher, G.; Celar, F.A.; Kos, K.; Knific, T.; Jakovac-Strajn, B. Occurrence of Alternaria and other toxins in cereal grains intended for animal feeding collected in Slovenia: A three-year study. Toxins 2021, 13, 304. [Google Scholar] [CrossRef]
- Waterford, C.J.; Ren, Y.; Lee, B.H.; Mahon, D.; Ryan, R.F. Carbonyl sulphide and ethyl formate update. In Proceedings of the 2004 Annual International Research Conference on Methyl Bromide Alternatives and Emissions Reductions, Orlando, FL, USA, 31 October–3 November 2004; Volume 31, pp. 60–61. [Google Scholar]
- Ren, Y.L.; Lee, B.H.; Padovan, B. Penetration of methyl bromide, sulfuryl fluoride, ethanedinitrile and phosphine into timber blocks and the sorption rate of the fumigants. J. Stored Prod. Res. 2011, 47, 63–68. [Google Scholar] [CrossRef]
- Noots, I.; Delcour, J.A.; Michiels, C.W. From field barley to malt: Detection and specifi cation of microbial activity for quality aspects. Crit. Rev. Microbiol. 1999, 25, 121–153. [Google Scholar] [CrossRef]
- Utama, I.M.S.; Wills, R.B.; Ben-Yehoshua, S.; Kuek, C. In vitro efficacy of plant volatiles for inhibiting the growth of fruit and vegetable decay microorganisms. J. Agric. Food Chem. 2002, 50, 6371–6377. [Google Scholar] [CrossRef]
- Lastauskienė, E.; Zinkevičienė, A.; Girkontaitė, I.; Kaunietis, A.; Kvedarienė, V. Formic acid and acetic acid induce a programmed cell death in pathogenic Candida species. Curr. Microbiol. 2014, 69, 303–310. [Google Scholar] [CrossRef]
- Revis, H.C.; Waller, D.A. Bactericidal and fungicidal activity of ant chemicals on feather parasites: An evaluation of anting behavior as a method of self-medication in songbirds. Auk 2004, 121, 1262–1268. [Google Scholar] [CrossRef]
- Yan, D.; Liu, J.; Wang, X.; Fang, W.; Li, Y.; Cao, A.; Wang, Q. A review on the mechanisms of fumigant action. New Plant Prot. 2025, 2, e27. [Google Scholar] [CrossRef]
- Islam, T.; Danishuddin Tamanna, N.T.; Matin, M.N.; Barai, H.R.; Haque, M.A. Resistance mechanisms of plant pathogenic fungi to fungicide, environmental impacts of fungicides, and sustainable solutions. Plants 2024, 13, 2737. [Google Scholar] [CrossRef]

| Names | Blast Sequences with the Highest Identity (%) | GenBank Accession Number |
|---|---|---|
| G01 | Alternaria infectoria (99.83%) | PP429847.1 |
| G02 | Alternaria infectoria (100%) | MW446954.1 |
| G03 | Alternaria infectoria (100%) | PP429847.1 |
| G04 | Alternaria infectoria (100%) | LN809032.1 |
| G05 | Penicillium sp. 1 (99.95%) | MK450671.1 |
| G06 | Penicillium sp. 2 (99.95%) | MH861314.1 |
| G07 | Epicoccum nigrum (100%) | MK460967.1 |
| G08 | Fusarium chlamydosporum (99.82%) | ON074988.1 |
| G09 | Fusarium chlamydosporum (100%) | ON074991.1 |
| G10 | Epicoccum nigrum (100%) | AJ279486.1 |
| G11 | Fusarium sp. (100%) | MF509746.1 |
| G12 | Aureobasidium sp. 1 (99.82%) | ON074960.1 |
| G13 | Pyrenophora teres (100%) | MK450003.1 |
| G14 | Aureobasidium sp. 2 (100%) | JK984782.1 |
| G15 | Pleiochaeta setosa (100%) | EU167563.1 |
| G16 | Cladosporium sp. (100%) | MN313285.1 |
| G17 | Aureobasidium sp. 2 (100%) | JK984782.1 |
| G18 | Curvularia sp. (99.82%) | MN215655.1 |
| G19 | Epicoccum nigrum (99.81%) | OM363478.1 |
| G20 | Didymella prosopidis (100%) | ON682327.1 |
| G21 | Rhizopus arrhizus (100%) | MW821588.1 |
| G22 | Nigrospora oryzae (100%) | JN207354.1 |
| Fungi Names | Ethyl Formate Treatment * | Colony Size of Control Group | ||
|---|---|---|---|---|
| Width (cm) | Length (cm) | Area (cm2) | ||
| A. infectoria (G01) | - | 2.7 | 2.7 | 22.9 |
| A. infectoria (G02) | - | 2.7 | 2 | 17.0 |
| A. infectoria (G03) | - | 3 | 2.7 | 25.4 |
| A. infectoria (G04) | - | 2.2 | 1.5 | 10.4 |
| Penicillium sp. 1 (G05) | - | 9.0 | 9.0 | 254.5 |
| Penicillium sp. 2 (G06) | + | 9.0 | 9.0 | 254.5 |
| E. nigrum (G07) | - | 2.8 | 2.2 | 19.4 |
| F. chlamydosporum (G08) | - | 2.7 | 2.2 | 18.7 |
| F. chlamydosporum (G09) | + | 2.5 | 2.0 | 15.7 |
| E. nigrum (G10) | - | 3.2 | 3.3 | 33.2 |
| Fusarium sp. (G11) | - | 2.0 | 1.5 | 9.4 |
| Aureobasidium sp. 1 (G12) | - | 2.0 | 1.8 | 11.3 |
| P. teres/graminea (G13) | - | 1.7 | 1.5 | 8.0 |
| Aureobasidium sp. 2 (G14) | - | 2.3 | 2.4 | 17.3 |
| P. setosa (G15) | - | 2.6 | 2.4 | 19.6 |
| Cladosporium sp. (G16) | - | 1.3 | 2.0 | 8.2 |
| Aureobasidium sp. 2 (G17) | - | 1.7 | 1.7 | 9.1 |
| Curvularia sp. (G18) | - | 3.0 | 3.3 | 31.1 |
| E. nigrum (G19) | - | 4.7 | 4.0 | 59.1 |
| D. prosopidis (G20) | - | 3.0 | 3.0 | 28.3 |
| R. arrhizus (G21) | + | 9.0 | 9.0 | 254.5 |
| N. oryzae (G22) | - | 9.0 | 9.0 | 254.5 |
| Selected Fungi | Inhibition Rate % | ||||
|---|---|---|---|---|---|
| 1.4 mmol/L | 2.4 mmol/L | 4.1 mmol/L | 5.4 mmol/L | 10.8 mmol/L | |
| A. infectoria | 26 ± 9% | 100% | 100% | 100% | 100% |
| Penicillium sp. 2 | 0% | 0% | 0% | 0% | 98 ± 2% |
| F. chlamydosporum | 16 ± 12% | 63 ± 4% | 85 ± 12% | 100% | 100% |
| R. arrhizus | 0% | 0% | 0% | 100% | 100% |
| Selected Fungi | Inhibition Rate % | ||||
|---|---|---|---|---|---|
| 0.01 mmol/L | 0.02 mmol/L | 0.04 mmol/L | 0.08 mmol/L | 0.18 mmol/L | |
| A. infectoria | 17 ± 9% | 16 ± 14% | 100% | 100% | 100% |
| Penicillium sp. 2 | 0% | 0% | 0% | 100% | 100% |
| F. chlamydosporum | 31 ± 10% | 26 ± 1% | 55 ± 6% | 88 ± 21% | 100% |
| R. arrhizus | 0% | 0% | 100% | 100% | 100% |
Disclaimer/Publisher’s Note: The statements, opinions and data contained in all publications are solely those of the individual author(s) and contributor(s) and not of MDPI and/or the editor(s). MDPI and/or the editor(s) disclaim responsibility for any injury to people or property resulting from any ideas, methods, instructions or products referred to in the content. |
© 2025 by the authors. Licensee MDPI, Basel, Switzerland. This article is an open access article distributed under the terms and conditions of the Creative Commons Attribution (CC BY) license (https://creativecommons.org/licenses/by/4.0/).
Share and Cite
Barkat, E.; Du, X.; Kim, J.-R.; Wang, Z.; Lee, B.-H.; Uaraboa, A.; Uaraboa, E.; Kim, B.-S. A Novel Approach for Fungal Control with Ethyl Formate in Barley and Its Impact on Germination. Agriculture 2025, 15, 748. https://doi.org/10.3390/agriculture15070748
Barkat E, Du X, Kim J-R, Wang Z, Lee B-H, Uaraboa A, Uaraboa E, Kim B-S. A Novel Approach for Fungal Control with Ethyl Formate in Barley and Its Impact on Germination. Agriculture. 2025; 15(7):748. https://doi.org/10.3390/agriculture15070748
Chicago/Turabian StyleBarkat, Eman, Xin Du, Jun-Ran Kim, Zhengyan Wang, Byung-Ho Lee, Abrar Uaraboa, Esra Uaraboa, and Bong-Su Kim. 2025. "A Novel Approach for Fungal Control with Ethyl Formate in Barley and Its Impact on Germination" Agriculture 15, no. 7: 748. https://doi.org/10.3390/agriculture15070748
APA StyleBarkat, E., Du, X., Kim, J.-R., Wang, Z., Lee, B.-H., Uaraboa, A., Uaraboa, E., & Kim, B.-S. (2025). A Novel Approach for Fungal Control with Ethyl Formate in Barley and Its Impact on Germination. Agriculture, 15(7), 748. https://doi.org/10.3390/agriculture15070748








